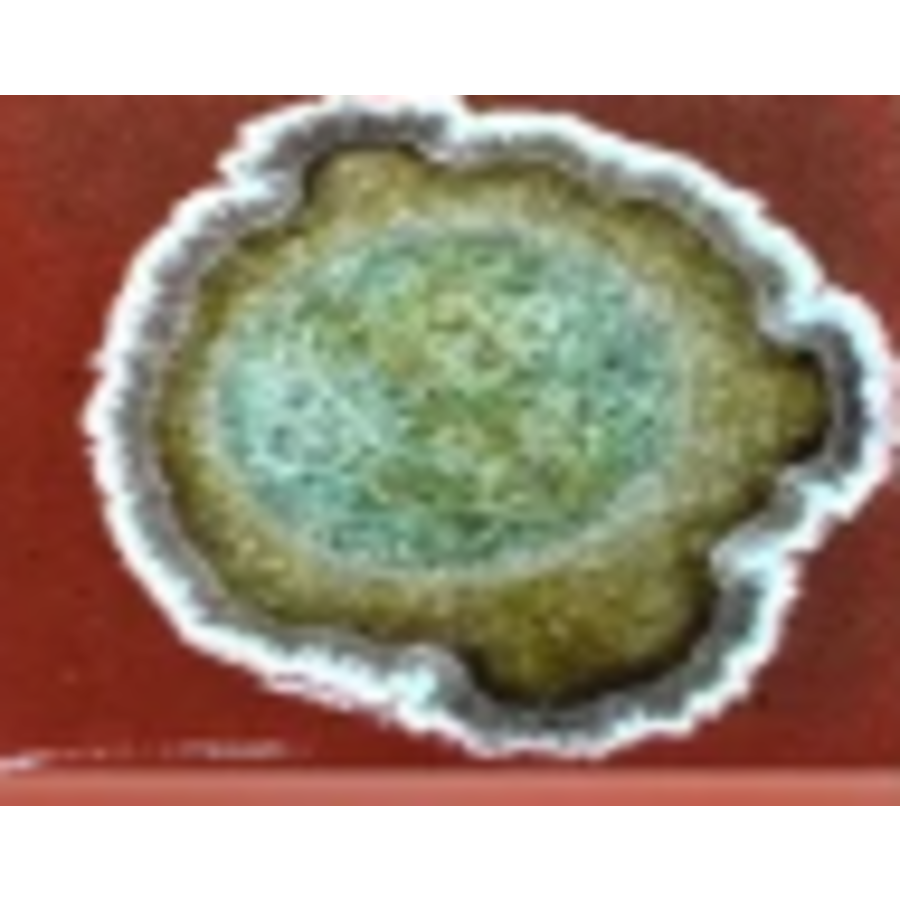
Pottery Sphere Ornament

- All products are added to your cart.
$17.99
- Article code 021749